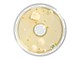
Sartorius Libra Elektronik

BACTair™mediji su ready-to-connect agar mediji za mikrobiološku kontrolu zraka s MD8 Airport uzorkivačem zraka ("impaction metodom"). Sustav omogućuje utjecaj na medij, budući da sam medij djeluje kao sakupljač. Metalna sita ili metalni sakupljači s utorima, koji se moraju sterilizirati za rutinsko uzorkovanje aerobnih mikroorganizama na redovnoj osnovi postali su stvar prošlosti sa BACTair™ medijima.
